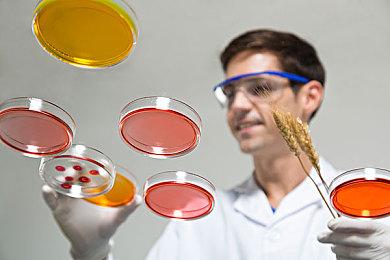
深圳湾实验室成立智囊团 五年内将建150个研究团队

备案编号:粤ICP备16092393号
互联网新闻信息服务许可证 4412006004
增值电信业务经营许可证 粤B1.B2-20062024
信息网络传播视听节目许可证1906154
网络文化经营许可证 粤网文[2017]11007-2832号
网络出版服务许可证 (署)网出证(粤)字第058号
廉政监督电话:(0755)83515516
报料热线:(0755)83518877
广播电视节目制作经营许可证 (粤)字第01775号
深圳新闻网传媒股份有限公司版权所有,未经书面授权禁止使用COPYRIGHT © BY WWW.SZNEWS.COM ALL RIGHTS RESERVED




























78e7fd86-8322-42ba-9adc-304993b96b55.png.2)
1fe1480a-7b44-43e5-bc62-224097b67e86.png.2)
0d1be410-8187-4098-ab22-5e3012f3b49a.png.2)
3a94ff6a-f818-4409-8c32-f7c0182321cf.png.2)

4ad24e0e-f618-486d-8eb4-6b10e45b3b5e.png.2)
34455ce2-0fc9-4b9b-bf12-c8508ebbcce3.png.2)
fd007307-4509-4ca4-af37-0717db80c3a8ea52283f-bbaa-49d3-adf7-dd14678d8007.png.2)



f06b1047-fd55-45d4-9d66-6eecdef257b6.png.2)
60ea5341-ca94-4473-8c3a-462b3cb7bdcf062ac51e-66d3-487d-9079-a514dc78d309.jpg.2)



























f2123937-7a79-4da3-a314-a0f9ddc6afb4.jpeg.2)




























e9e39fba-d6fd-4cbd-9688-cddf880903b6.jpeg.2)


9a8d9676-a4b0-4692-a7f6-f5b48a46c8b5.jpg.2)










































f28cfea2-c527-4627-9315-cfc71679717a.png.2)
















50bf3d26-987c-4e1b-a61b-a3fb2345fcdd.png.2)






















735da89c-a1aa-4cee-aa9a-11888a370a28.jpg.2)
28dec2c1-d5ec-495f-be72-f06d29bd153e.jpg.2)
334b968c-fadd-4896-8506-1253d50aad95.jpg.2)

039e31b6-6c59-4616-bb4c-8a53c12260c0.jpeg.2)

f1a763df-41b3-4a06-8df2-b548f0e19900.png.2)
a18a923b-1e6a-444d-b69e-6d673a1f5049.png.2)

399d6a76-098f-41c5-ae2e-42966f0af348.jpeg.2)
2fd451b2-e1a3-4621-ad98-d49b2a79525d.png.2)
eb834278-2e06-45b9-8cdf-451a9edcf365.jpg.2)
1c5a6636-6970-4578-a35a-0c76a1a5195a.jpg.2)
92f84fd6-e8c6-4117-bac4-376b8d6f794d.jpg.2)
cf826d96-4b23-410a-9663-efbf10d74e18.jpg.2)
e101f0ec-7ca3-4132-909e-40f3a993b3b3.png.2)
a45e4be0-99ea-4f8e-a2ef-bc02ecb80076.jpeg.2)
a28b342c-19c2-4ea6-9f62-467a7350aeea.jpg.2)
7697c533-df92-40ee-b426-fdbdc9c6ec01.jpg.2)
c3c404b5-b786-47bb-9fc9-0da9ad398347.jpg.2)
99362d9f-ad50-436a-975d-5228592a5920.jpg.2)
877d0f4e-8ef1-486a-b894-3f07c59b4486.jpg.2)
2fc668a1-d7ee-4bb6-86c8-b3f32189cb60.jpg.2)
e21b212f-6c8a-439e-8337-7ed837d19e25.jpg.2)
dd192b0a-09f8-4645-a808-5d4e2acb00f9.jpg.2)
bc777d87-0c30-4133-a593-78046c5e780d.jpg.2)





b6c35aa7-7a64-4fbe-ba34-dcc06b7d027a.png.2)






cbb42d31-05a3-4183-b215-372c3611e5ab.jpeg.2)

















































































954b1227-032b-4cbd-b64c-a05538242c47.jpg.2)



























dc3a1d60-ac58-4afc-8c4f-5369dd3fc243.jpg.2)

84764dff-391d-494a-bec6-f4763e39b0c1.jpg.2)
1cd5ad29-c3e5-48fe-bba4-9ae28e8a789e.jpg.2)










f3c86041-4415-47eb-9f1f-56859618aea4.jpg.2)
7a065210-b658-4a00-8b97-68d58ec3f2c9.png.2)






















































































































































































































































































































a1e1b1ab-6d7a-4cf3-9b45-07f4c1646f2b.jpg.2)







































































